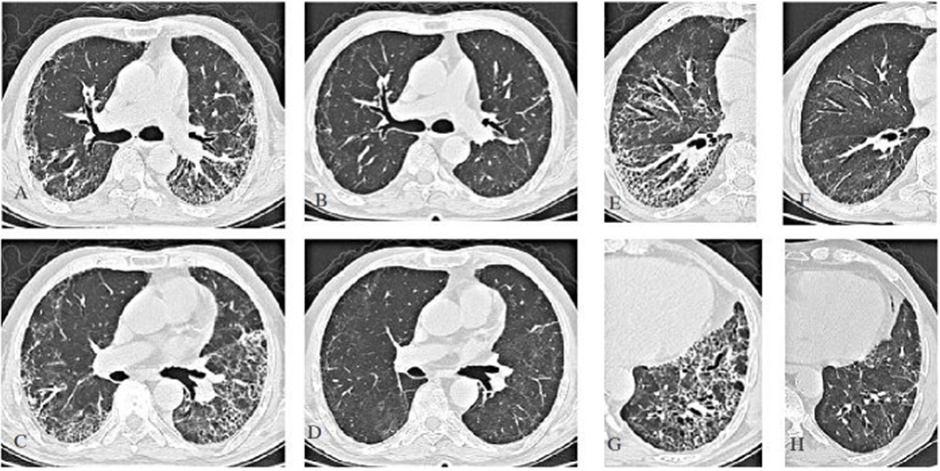
a-c-e-g: CT ngực của bệnh nhân có biểu hiện khó thở ở tuần 13 sau nhiễm COVID-19. b-d-f-h: Sự thoái lui đáng kể các tổn thương tuần thứ 25 sau khi điều trị bằng steroid. (From archives of Aydın Yılmaz)

Di chứng hô hấp hậu COVID 19
Di chứng hô hấp hậu COVID 19
1. Diễn tiến
Dựa trên những hiểu biết về viêm phổi tại cộng đồng, bệnh nhân được chẩn đoán viêm phổi do COVID19 sẽ hạ sốt trong vòng khoảng 1 tuần. Các phàn nàn về đau ngực và khạc đờm sẽ giảm trong 4 tuần, ho và tình trạng khó thở sẽ giảm đi nhiều trong 6 tuần. Thông thường sau 3 tháng, đa số các triệu chứng sẽ được cải thiện và hầu hết mọi người trở lại tình trạng bình thường trong vòng 6 tháng. Tuy nhiên vẫn có một số người nguy cơ cao mắc phải những di chứng phổi hậu COVID.
Dựa trên những hiểu biết về viêm phổi tại cộng đồng, bệnh nhân được chẩn đoán viêm phổi do COVID19 sẽ hạ sốt trong vòng khoảng 1 tuần. Các phàn nàn về đau ngực và khạc đờm sẽ giảm trong 4 tuần, ho và tình trạng khó thở sẽ giảm đi nhiều trong 6 tuần. Thông thường sau 3 tháng, đa số các triệu chứng sẽ được cải thiện và hầu hết mọi người trở lại tình trạng bình thường trong vòng 6 tháng. Tuy nhiên vẫn có một số người nguy cơ cao mắc phải những di chứng phổi hậu COVID.
| Nhóm bệnh nhân nguy cơ cao bị di chứng phổi hậu COVID 19 - Tuổi > 60 - Hút thuốc lá - Nhiều bệnh kèm: Đái tháo đường, tăng huyết áp, bệnh mạch vành - Có bệnh hô hấp từ trước: hen, COPD, bệnh phổi kẽ... - Cần oxy liệu pháp tại nhà - Cần thông khí cơ học xâm lấn/ không xâm lấn trong quá trình điều trị COVID |
Hô hấp là cơ quan bị ảnh hưởng nghiêm trọng nhất bởi COVID-19. Một số cơ chế gây nên di chứng phổi hậu COVID đã được tóm lược

(A)Viêm mãn tính tạo ra liên tục các cytokine tiền viêm và các gốc oxy hóa (ROS) được giải phóng vào mô xung quanh và dòng máu. (B) Tổn thương nội mô gây ra sự kích hoạt các nguyên bào sợi (fibroblasts), các nguyên bào này lắng đọng collagen và fibronectin, dẫn đến những thay đổi xơ hóa. (C) Tổn thương nội mô, kích hoạt bổ thể, hoạt hóa tiểu cầu và tương tác giữa tiểu - bạch cầu, giải phóng các cytokine tiền viêm, phá vỡ các con đường đông máu bình thường cùng với tình trạng thiếu oxy có thể dẫn đến sự phát triển của trạng thái tăng viêm và tăng đông kéo dài, làm tăng nguy cơ huyết khối.
Sau khoảng bốn tuần đầu tiên, các trường hợp bệnh nặng hầu hết đều có thể phục hồi, nhưng tổn thương cơ quan có thể trở nên dai dẳng với các triệu chứng kéo dài, sinh lí bệnh đa dạng. Các biến chứng này bao gồm nhiễm trùng thứ phát hậu COVID, rối loạn thăm dò chức năng hô hấp, huyết khối - thuyên tắc phổi, tăng áp phổi, và xơ phổi
2.1. Nhiễm trùng thứ phát hậu COVID có thể làm thay đổi quá trình phục hồi bệnh. Sự rối loạn trong điều hòa cơ chế miễn dịch quá mức và trạng thái ức chế miễn dịch xảy trước khi nó tiến triển thành tổn thương cơ quan sau pha đáp ứng viêm cấp ở bệnh nhân COVID-19, tương tự như trạng thái ức chế miễn dịch quá mức sau nhiễm trùng huyết.
2.2. Sự suy giảm chức năng hô hấp hậu COVID-19 có thể kéo dài tới 12 tháng, và thậm chí có thể trở thành dai dẳng với xơ phổi và bệnh lí mạch máu. Thấy rõ nhất là khả năng khuếch tán khí (carbon monoxide diffusion capacity) giảm , ngay cả khi thể tích phổi bình thường. Sự suy yếu các cơ hô hấp, tiến triển của xơ hóa, thuyên tắc, bệnh mạch máu, các bệnh nền và phải trải qua chăm sóc tích cực là những yếu tố nguy cơ làm suy giảm chức năng phổi.
2.3. Huyết khối, thuyên tắc phổi: Các biến đổi bệnh lí mạch máu nhỏ, huyết khối lớn và nhỏ thường xảy ra ở giai đoạn sớm của COVID 19, tình trạng này phổ biến hơn các bệnh do virus khác. Những tổn thương, tình trạng viêm và thiếu oxy xảy ra trong quá trình nhiễm virus sẽ kích hoạt dòng thác đông máu, làm hoạt hóa tiểu cầu cùng với sự gia tăng chất trung gian như như yếu tố von Willebrand và P-selectin. Tăng hoạt hóa bổ thể, tự kháng thể cũng có thể góp phần vào quá trình này. Tình trạng tăng đông có thể kéo dài qua giai đoạn hậu COVID và có thể theo dõi qua D-dimer - chỉ số hình thành thoái giáng fibrin đang diễn tiến. Sự ứ đọng máu, tổn thương nội mạc và quá trình tăng đông (tam giác Virchow) có thể giúp hiểu rõ cơ chế thuyên tắc huyết khối. Tăng đông còn có thể do quá trình viêm kéo dài ở một số bệnh nhân với sự gia tăng của IL-6 và Lipocalin 2, và sự góp phần của kháng thể kháng phospholipid.
2.4. Xơ phổi: Biến chứng nghiêm trọng nhất của hậu COVID. Xơ phổi có thể được phát hiện từ giai đoạn sớm bất kể tình trạng và mức độ nghiêm trọng của bệnh. SARS-CoV 2 làm tăng TGF-b là yếu tố quan trọng nhất trong quá trình phục hồi tổn thương nhu mô và thoái triển viêm, đây cũng được cho là cytokine đóng vai trò quan trọng nhất trong quá trình tiến triển xơ phổi ở thời kì hậu COVID. Sự gia tăng ái lực giữa spike protein SARS-CoV 2 với thụ thể ACE2 (angiotensin converting enzyme 2) dẫn đến giảm sự biểu hiện của ACE2, tăng Angiotensin II (ANG II). ANG II là một peptid co mạch mạch liên quan trực tiếp đến viêm và xơ hóa. Ngoài vai trò điều hòa huyết áp, nó còn làm rối loạn chữa lành tổn thương và tiến tiến triển xơ phổi bằng cách: (i) tăng sản xuất các cytokines tiền viêm như IL 6, IL 8, (ii) tăng sản xuất các gốc oxy hóa tác động đến tế bào phế nang và (iii) hoạt hóa TGF-b. Chính những tác động này sẽ làm tăng sinh các nguyên bào sợi (fibroblast), di chuyển đến nhu mô phổi, biến đổi thành myofibroblasts, hoạt hóa và cuối cùng là tích lũy chất nền ngoại bào (extracellular matrix). Hai yếu tố do điều trị có thể dẫn đến xơ phổi ở những người sống sót sau khi nhiễm COVID nặng đó là ngộ độc oxy và các tổn thương phổi do thở máy (ventilator induced lung injury).
Sau khoảng bốn tuần đầu tiên, các trường hợp bệnh nặng hầu hết đều có thể phục hồi, nhưng tổn thương cơ quan có thể trở nên dai dẳng với các triệu chứng kéo dài, sinh lí bệnh đa dạng. Các biến chứng này bao gồm nhiễm trùng thứ phát hậu COVID, rối loạn thăm dò chức năng hô hấp, huyết khối - thuyên tắc phổi, tăng áp phổi, và xơ phổi
2.1. Nhiễm trùng thứ phát hậu COVID có thể làm thay đổi quá trình phục hồi bệnh. Sự rối loạn trong điều hòa cơ chế miễn dịch quá mức và trạng thái ức chế miễn dịch xảy trước khi nó tiến triển thành tổn thương cơ quan sau pha đáp ứng viêm cấp ở bệnh nhân COVID-19, tương tự như trạng thái ức chế miễn dịch quá mức sau nhiễm trùng huyết.
2.2. Sự suy giảm chức năng hô hấp hậu COVID-19 có thể kéo dài tới 12 tháng, và thậm chí có thể trở thành dai dẳng với xơ phổi và bệnh lí mạch máu. Thấy rõ nhất là khả năng khuếch tán khí (carbon monoxide diffusion capacity) giảm , ngay cả khi thể tích phổi bình thường. Sự suy yếu các cơ hô hấp, tiến triển của xơ hóa, thuyên tắc, bệnh mạch máu, các bệnh nền và phải trải qua chăm sóc tích cực là những yếu tố nguy cơ làm suy giảm chức năng phổi.
2.3. Huyết khối, thuyên tắc phổi: Các biến đổi bệnh lí mạch máu nhỏ, huyết khối lớn và nhỏ thường xảy ra ở giai đoạn sớm của COVID 19, tình trạng này phổ biến hơn các bệnh do virus khác. Những tổn thương, tình trạng viêm và thiếu oxy xảy ra trong quá trình nhiễm virus sẽ kích hoạt dòng thác đông máu, làm hoạt hóa tiểu cầu cùng với sự gia tăng chất trung gian như như yếu tố von Willebrand và P-selectin. Tăng hoạt hóa bổ thể, tự kháng thể cũng có thể góp phần vào quá trình này. Tình trạng tăng đông có thể kéo dài qua giai đoạn hậu COVID và có thể theo dõi qua D-dimer - chỉ số hình thành thoái giáng fibrin đang diễn tiến. Sự ứ đọng máu, tổn thương nội mạc và quá trình tăng đông (tam giác Virchow) có thể giúp hiểu rõ cơ chế thuyên tắc huyết khối. Tăng đông còn có thể do quá trình viêm kéo dài ở một số bệnh nhân với sự gia tăng của IL-6 và Lipocalin 2, và sự góp phần của kháng thể kháng phospholipid.
2.4. Xơ phổi: Biến chứng nghiêm trọng nhất của hậu COVID. Xơ phổi có thể được phát hiện từ giai đoạn sớm bất kể tình trạng và mức độ nghiêm trọng của bệnh. SARS-CoV 2 làm tăng TGF-b là yếu tố quan trọng nhất trong quá trình phục hồi tổn thương nhu mô và thoái triển viêm, đây cũng được cho là cytokine đóng vai trò quan trọng nhất trong quá trình tiến triển xơ phổi ở thời kì hậu COVID. Sự gia tăng ái lực giữa spike protein SARS-CoV 2 với thụ thể ACE2 (angiotensin converting enzyme 2) dẫn đến giảm sự biểu hiện của ACE2, tăng Angiotensin II (ANG II). ANG II là một peptid co mạch mạch liên quan trực tiếp đến viêm và xơ hóa. Ngoài vai trò điều hòa huyết áp, nó còn làm rối loạn chữa lành tổn thương và tiến tiến triển xơ phổi bằng cách: (i) tăng sản xuất các cytokines tiền viêm như IL 6, IL 8, (ii) tăng sản xuất các gốc oxy hóa tác động đến tế bào phế nang và (iii) hoạt hóa TGF-b. Chính những tác động này sẽ làm tăng sinh các nguyên bào sợi (fibroblast), di chuyển đến nhu mô phổi, biến đổi thành myofibroblasts, hoạt hóa và cuối cùng là tích lũy chất nền ngoại bào (extracellular matrix). Hai yếu tố do điều trị có thể dẫn đến xơ phổi ở những người sống sót sau khi nhiễm COVID nặng đó là ngộ độc oxy và các tổn thương phổi do thở máy (ventilator induced lung injury).
 | ECM: chất nền ngoại bào (extracellular matrix) VALI: Tổn thương phổi do thở máy (ventilator associated lung injury) |
Sự tồn tại của các triệu chứng hô hấp khi nhiễm COVID 19 kéo dài hơn 12 tuần và không thể giải thích được bằng một chẩn đoán khác, tình trạng này gọi là di chứng hô hấp hậu COVID. Thường gặp nhất là khó thở và ho. Một nghiên cứu trên 143 bệnh nhân cho thấy 43.4% bệnh nhân vẫn bị khó thở ở ngày thứ 60 kể từ khi khởi phát bệnh. Ho kéo dài hậu COVID gặp ở 7-10%.
Đánh giá ban đầu bệnh nhân nghi ngờ di chứng hô hấp hậu COVID 19

* ECG và/hoặc siêu âm tim có thể được cân nhắc trong những ca có đau ngực cấp
** Sau 1 tháng đầu, SpO2 <94% được coi là bất thường
4. Điều trị di chứng hô hấp hậu COVID
Điều trị di chứng hô hấp sau COVID bao gồm điều trị bệnh lý cụ thể như xơ phổi, thuyên tắc phổi, nhiễm trùng thứ phát… Cũng như kiểm soát các triệu chứng hô hấp.
4.1. Ho mạn tính
Ho là một trong những triệu chứng khởi đầu của COVID, và tình trạng ho kéo dài hậu COVID cũng thường xuyên gặp. Không như ho sau cảm cúm, ho mạn tính sau COVID thường kèm theo các biểu hiện đa hệ thống, chỉ ra cơ chế bệnh sinh đa yếu tố gây nên triệu chứng này. Ho có thể do sự xâm nhập của SARS CoV-2 vào tế bào thần kinh cảm giác phế vị, hoặc từ phản ứng viêm thần kinh, hoặc cả hai, dẫn đến tăng nhạy cảm cung phản xạ ho ngoại vi và trung ương. Cần phân biệt với các nguyên nhân khác: GERD, hen, viêm mũi dị ứng...
Theo hướng dẫn của NICE, thuốc ho dẫn xuất opioid được khuyến cáo nhưng cần chú ý khả năng gây nghiện và tác động lên hệ thần kinh. Steroid đường uống hoặc hít có thể dùng cho bệnh nhân hen. Ho kháng trị hoặc không thể giải thích trong hậu COVID có thể từ viêm thần kinh dẫn đến quá mẫn thanh khí phế quản. Những tác nhân neuromodulator như gabapentin và pregabalin có thể được khuyến cáo. Thuốc kháng muscarinic như tiotropium làm giảm ho sau nhiễm virus đường hô hấp trên. Âm ngữ trị liệu (speech and language therapy) như một phần của một liệu pháp đa phương thức phối hợp với các khía cạnh khác của phục hồi chức năng phổi có thể giúp bệnh nhân hồi phục.
4.2. Khó thở
Khó thở có thể được điều trị bằng việc điều trị các nguyên nhân nền gây ra: xơ phổi, thuyên tắc phổi, nhiễm trùng thứ phát...
Ở những bệnh nhân giảm oxy máu kéo dài hậu COVID, liệu pháp oxy có thể giúp cải thiện. Phục hồi chức năng hô hấp được khuyến khích cho những bệnh nhân bị COVID 19, những bệnh nhân vừa và nặng, đặc biệt là những người vẫn còn triệu chứng sau giai đoạn cấp.
4.3. Tổn thương hang hậu COVID và quản lí
Hình ảnh đặc trưng của COVID 19: Đám kính mờ ngoại biên (ground-glass opacities) ở một hoặc hai bên phổi, đám mờ lưới mịn (fine reticular opacitie), dày thành mạch máu.
Tổn thương hang thường hiếm gặp trong viêm phổi do virus (gổm cả SARS- CoV và MERS-CoV), ngay cả khi bệnh nặng, tiến triển. Tuy nhiên tổn thương này đã được công bố ở những ca có triệu chứng kéo dài (4-12 tuần). Nghiên cứu của Zoumot đã báo cáo 12/689 ca (1.7%) xuất hiện tổn thương hang vào ngày 36 (21-54 ngày) và tất cả bệnh nhân đều đều có tổn thương kính mờ ngoại biên hai bên, hầu hết đều có đông đặc phổi và hình ảnh khí phế quản đồ, tổn thương dạng đá lát cùng với dày vách gian tiểu thùy có ở ½ bệnh nhân. Tocilizumab và liệu pháp steroid gây nên ức chế miễn dịch, được sử dụng cho những bệnh nhân viêm phổi COVID nặng. Có 4 bệnh nhân tìm được vi khuẩn gây tổn thương hang, ho ra máu và tràn khí màng phổi phát triển ở 2 bệnh nhân và 4 bệnh nhân có các dấu hiệu hình ảnh phù hợp với aspergillosis xâm lấn. Tác giả đã mô tả sự phát triển tổn thương hang ở những bệnh nhân này do nhiều nguyên nhân như: Vi khuẩn và đồng nhiễm nấm, tác động ức chế miễn dịch của glucocorticosteroid và Tocilizumab, thuyên tắc tĩnh mạch và nhồi máu phổi.
Hiện chưa có tiêu chuẩn chẩn đoán hoặc điều trị các tổn thương hang giai đoạn hậu COVID, tuy nhiên cần chú ý đến nhiễm nấm đặc biệt là aspergillosis, lao phổi, các xét nghiệm sinh hóa, vi sinh nên được thực hiện và điều trị thích hợp phải được bắt đầu càng sớm càng tốt.
** Sau 1 tháng đầu, SpO2 <94% được coi là bất thường
4. Điều trị di chứng hô hấp hậu COVID
Điều trị di chứng hô hấp sau COVID bao gồm điều trị bệnh lý cụ thể như xơ phổi, thuyên tắc phổi, nhiễm trùng thứ phát… Cũng như kiểm soát các triệu chứng hô hấp.
4.1. Ho mạn tính
Ho là một trong những triệu chứng khởi đầu của COVID, và tình trạng ho kéo dài hậu COVID cũng thường xuyên gặp. Không như ho sau cảm cúm, ho mạn tính sau COVID thường kèm theo các biểu hiện đa hệ thống, chỉ ra cơ chế bệnh sinh đa yếu tố gây nên triệu chứng này. Ho có thể do sự xâm nhập của SARS CoV-2 vào tế bào thần kinh cảm giác phế vị, hoặc từ phản ứng viêm thần kinh, hoặc cả hai, dẫn đến tăng nhạy cảm cung phản xạ ho ngoại vi và trung ương. Cần phân biệt với các nguyên nhân khác: GERD, hen, viêm mũi dị ứng...
Theo hướng dẫn của NICE, thuốc ho dẫn xuất opioid được khuyến cáo nhưng cần chú ý khả năng gây nghiện và tác động lên hệ thần kinh. Steroid đường uống hoặc hít có thể dùng cho bệnh nhân hen. Ho kháng trị hoặc không thể giải thích trong hậu COVID có thể từ viêm thần kinh dẫn đến quá mẫn thanh khí phế quản. Những tác nhân neuromodulator như gabapentin và pregabalin có thể được khuyến cáo. Thuốc kháng muscarinic như tiotropium làm giảm ho sau nhiễm virus đường hô hấp trên. Âm ngữ trị liệu (speech and language therapy) như một phần của một liệu pháp đa phương thức phối hợp với các khía cạnh khác của phục hồi chức năng phổi có thể giúp bệnh nhân hồi phục.
4.2. Khó thở
Khó thở có thể được điều trị bằng việc điều trị các nguyên nhân nền gây ra: xơ phổi, thuyên tắc phổi, nhiễm trùng thứ phát...
Ở những bệnh nhân giảm oxy máu kéo dài hậu COVID, liệu pháp oxy có thể giúp cải thiện. Phục hồi chức năng hô hấp được khuyến khích cho những bệnh nhân bị COVID 19, những bệnh nhân vừa và nặng, đặc biệt là những người vẫn còn triệu chứng sau giai đoạn cấp.
4.3. Tổn thương hang hậu COVID và quản lí
Hình ảnh đặc trưng của COVID 19: Đám kính mờ ngoại biên (ground-glass opacities) ở một hoặc hai bên phổi, đám mờ lưới mịn (fine reticular opacitie), dày thành mạch máu.
Tổn thương hang thường hiếm gặp trong viêm phổi do virus (gổm cả SARS- CoV và MERS-CoV), ngay cả khi bệnh nặng, tiến triển. Tuy nhiên tổn thương này đã được công bố ở những ca có triệu chứng kéo dài (4-12 tuần). Nghiên cứu của Zoumot đã báo cáo 12/689 ca (1.7%) xuất hiện tổn thương hang vào ngày 36 (21-54 ngày) và tất cả bệnh nhân đều đều có tổn thương kính mờ ngoại biên hai bên, hầu hết đều có đông đặc phổi và hình ảnh khí phế quản đồ, tổn thương dạng đá lát cùng với dày vách gian tiểu thùy có ở ½ bệnh nhân. Tocilizumab và liệu pháp steroid gây nên ức chế miễn dịch, được sử dụng cho những bệnh nhân viêm phổi COVID nặng. Có 4 bệnh nhân tìm được vi khuẩn gây tổn thương hang, ho ra máu và tràn khí màng phổi phát triển ở 2 bệnh nhân và 4 bệnh nhân có các dấu hiệu hình ảnh phù hợp với aspergillosis xâm lấn. Tác giả đã mô tả sự phát triển tổn thương hang ở những bệnh nhân này do nhiều nguyên nhân như: Vi khuẩn và đồng nhiễm nấm, tác động ức chế miễn dịch của glucocorticosteroid và Tocilizumab, thuyên tắc tĩnh mạch và nhồi máu phổi.
Hiện chưa có tiêu chuẩn chẩn đoán hoặc điều trị các tổn thương hang giai đoạn hậu COVID, tuy nhiên cần chú ý đến nhiễm nấm đặc biệt là aspergillosis, lao phổi, các xét nghiệm sinh hóa, vi sinh nên được thực hiện và điều trị thích hợp phải được bắt đầu càng sớm càng tốt.

4.4. Bệnh đường dẫn khí nhỏ và quản lí
Sự tiến triển của bệnh đường dẫn khí nhỏ (Small airway disease SAD) trong hội chứng hậu COVID là một tình trạng lâm sàng rất mới. Một nghiên cứu của Cho JL và cộng sự trên 100 bệnh nhân, đã cho thấy có mối tương quan giữa bẫy khí được đo bằng cắt lớp vi tính lồng ngực định lượng (quantitative thorax computed tomography (CT)) và chức năng hô hấp. Nghiên cứu đã chỉ ra ra rằng bẫy khí được phát hiện trên CT có thể là một biomarker của bệnh lí đường dẫn khí nhỏ SAD.
Cơ chế bệnh lí này có thể được giải thích như sau: Thụ thể ACE2- tạo điều kiện cho SARS CoV2 xâm nhập vào tế bào, hiện diện khắp đường dẫn khí, kể cả đường dẫn khí nhỏ. SARS CoV2 có thể trực tiếp gây viêm đường dẫn khí nhỏ dù chỉ bị COVID nhẹ. SAD hậu COVID là kết quả của sự tổn thương đường dẫn khí nhỏ do quá trình sửa chữa kéo dài, mảnh vụn tế bào và/hoặc quá trình tạo chất nhầy bất thường . Đáp ứng miễn dịch do SARS-CoV-2 cũng có thể trực tiếp gây ra SAD ngay cả khi không bị nhiễm trùng. Sự tiến triển của SAD nhiều tháng sau khi nhiễm COVID cấp tính có thể dẫn đến tái cấu trúc đường thở và xơ phổi. Các nghiên cứu đa trung tâm, tiến cứu là cần thiết để hiểu rõ về tần suất SAD và khuyến cáo điều trị SAD hậu COVID 19.
Sự tiến triển của bệnh đường dẫn khí nhỏ (Small airway disease SAD) trong hội chứng hậu COVID là một tình trạng lâm sàng rất mới. Một nghiên cứu của Cho JL và cộng sự trên 100 bệnh nhân, đã cho thấy có mối tương quan giữa bẫy khí được đo bằng cắt lớp vi tính lồng ngực định lượng (quantitative thorax computed tomography (CT)) và chức năng hô hấp. Nghiên cứu đã chỉ ra ra rằng bẫy khí được phát hiện trên CT có thể là một biomarker của bệnh lí đường dẫn khí nhỏ SAD.
Cơ chế bệnh lí này có thể được giải thích như sau: Thụ thể ACE2- tạo điều kiện cho SARS CoV2 xâm nhập vào tế bào, hiện diện khắp đường dẫn khí, kể cả đường dẫn khí nhỏ. SARS CoV2 có thể trực tiếp gây viêm đường dẫn khí nhỏ dù chỉ bị COVID nhẹ. SAD hậu COVID là kết quả của sự tổn thương đường dẫn khí nhỏ do quá trình sửa chữa kéo dài, mảnh vụn tế bào và/hoặc quá trình tạo chất nhầy bất thường . Đáp ứng miễn dịch do SARS-CoV-2 cũng có thể trực tiếp gây ra SAD ngay cả khi không bị nhiễm trùng. Sự tiến triển của SAD nhiều tháng sau khi nhiễm COVID cấp tính có thể dẫn đến tái cấu trúc đường thở và xơ phổi. Các nghiên cứu đa trung tâm, tiến cứu là cần thiết để hiểu rõ về tần suất SAD và khuyến cáo điều trị SAD hậu COVID 19.

4.5. Tăng áp phổi
Tần suất tăng áp động mạch phổi (PAH) tăng lên ở những bệnh nhân nhiễm virus như HIV, dù cơ chế chưa được rõ. Ở COVID-19, thành động mạch phổi dày gấp đôi so với người nhiễm H1N1 được chỉ ra trong khám nghiệm tử thi. Mạch máu phổi dày lên trong COVID-19 được cho là có vai trò quan trọng trong suy hô hấp cấp tính, và dựa trên dựa trên kết quả này, có thể nghĩ rằng bệnh nhân đang phục hồi từ COVID-19 có thể dễ bị PAH và suy tim phải
4.6. Xơ phổi
Tần suất tăng áp động mạch phổi (PAH) tăng lên ở những bệnh nhân nhiễm virus như HIV, dù cơ chế chưa được rõ. Ở COVID-19, thành động mạch phổi dày gấp đôi so với người nhiễm H1N1 được chỉ ra trong khám nghiệm tử thi. Mạch máu phổi dày lên trong COVID-19 được cho là có vai trò quan trọng trong suy hô hấp cấp tính, và dựa trên dựa trên kết quả này, có thể nghĩ rằng bệnh nhân đang phục hồi từ COVID-19 có thể dễ bị PAH và suy tim phải
4.6. Xơ phổi
Số lượng nghiên cứu và các bài đánh viết viết về xơ phổi hậu COVID tăng lên từng ngày. Xơ hóa phổi hậu COVID hay còn được gọi là bệnh phổi kẽ hậu COVID (Post-COVID interstitial lung disease: PCILD) trong hầu hết các bài báo. Trong một bài báo được xuất bản từ Ấn Độ tháng 3-2021, PC-ILD được định nghĩa là 'cơn sóng thần sẽ theo sau trận động đất’. Theo bài báo này, hầu hết các thương tổn ở phổi đều lành mà không để lại di chứng, một số bệnh nhân sẽ lành với xơ hóa tối thiểu mà không tiến triển xấu thêm, và một số rất ít sẽ bị xơ phổi tiến triển và cần dùng thuốc chống xơ hóa. Tuổi cao, viêm phổi nặng, thời gian ở ICU và thông khí cơ học kéo dài, hút thuốc và tiền sử nghiện rượu mãn tính là một số yếu tố dự báo cho PC-ILD. Tăng CRP, IL-6 và LDH trong giai đoạn cấp tính có thể dẫn đến kích hoạt nguyên bào sợi tăng sinh trong quá trình sửa chữa tổn thương phổi.
Phòng ngừa PC ILD và điều trị: Để giảm thiểu những yếu tố nguy cơ tiến triển đến PC-ILD cần rút ngắn thời gian nằm ICU, tránh thở máy xâm nhập nếu có thể, nếu cần thì thở áp lực thấp, điều trị các bệnh kèm và ngăn ngừa nhiễm trùng thứ phát. Các lựa chọn điều trị sau được liệt kê dựa trên những bằng chứng hiện tại:
a. Thuốc kháng virus:
Có mối quan hệ chặt chẽ giữa tiến triển xơ phổi và tải lượng virus cao, hiệu quả của các phương pháp điều trị kháng virus sớm (remdesivir, favipiravir) để giảm tải lượng virus đã được chứng minh trong một số nghiên cứu. Sự cần thiết của thuốc kháng virus trong việc kiểm soát đại dịch là không thể chối cãi. Tuy nhiên, chưa có loại thuốc đặc hiệu nào được phát triển cho SARSCoV-2 và nhiều nghiên cứu đang được tiến hành để phát triển các loại thuốc hiệu quả
b. Thuốc kháng viêm:
Hiệu quả của steroid toàn thân đã được chứng minh trong điều trị bệnh nhân COVID nặng giai đoạn cấp. Tuy nhiên, chưa đủ bằng chứng để sử dụng steroid lâu dài ngăn ngừa PC-ILD. Vài nghiên cứu đề xuất dùng liều 20–30 mg /ngày prednisolone ngay khi có sự hiện diện của hình ảnh kính mờ lan tỏa cho đến khi có sự cải thiện hình ảnh học.
c. Thuốc chống xơ phổi
Như đã đề cập, các tổn thương phổi có thể hồi phục nên có thể theo dõi hình ảnh trong tối đa 3 tháng, không cần thiết phải vội vàng dùng thuốc chống xơ phổi. Nếu xơ phổi vẫn còn tồn tại vào cuối tuần thứ 12, có thể sử dụng thuốc chống xơ, dù hiện nay vẫn chưa có đủ bằng chứng. Pirfenidone hoặc Nintedanib nên được sử dụng trong ít nhất 1-3 tháng để có được đáp ứng. Đáp ứng thuốc chống xơ nên được đánh giá bằng HRCT, DLCO và 6MWT. Có thể thử sử dụng đồng thời steroid và thuốc chống xơ phổi, tuy nhiên kết quả lâu dài vẫn chưa được biết rõ.
d. Phục hồi chức năng hô hấp
Là điều trị then chốt, có thể áp dụng được tại nhà. Khi PC DIL gây hạ oxy máu, việc sử dụng oxy dài hạn và phục hồi chức năng tại nhà có thể giúp cải thiện tình trạng này
e. Các biện pháp hỗ trợ khác:
Chống đông, hỗ trợ tâm lí, hỗ trợ từ gia đình, chích ngừa cúm và viêm phổi là cần thiết cho đến khi bệnh nhân có thể di động hoàn toàn. Đánh giá, theo dõi các trường hợp PC ILD tiến triển để xem xét ghép phổi
4.7. Thuyên tắc phổi dự phòng và điều trị
Sau giai đoạn cấp, tình trạng tăng đông vẫn có thể kéo dài, vì vậy dự phòng lâu dài có thể được khuyến cáo trong các trường hợp bệnh nặng. Tuy nhiên, vấn đề này còn đang bàn cãi. Trường hợp bệnh nặng kèm theo thuyên tắc phổi, dùng thuốc chống đông là bắt buộc theo các khuyến cáo guideline cụ thể. Khuyến cáo nên đánh giá sự tiến triển của tăng áp phổi (pulmonary hypertension PHT) sau 12 tuần và ngừng điều trị sau 3 tháng nếu tăng áp phổi chưa phát triển. Cuối cùng, việc đo và theo dõi D-Dimer, cũng là một chất phản ứng giai đoạn cấp và không đặc hiệu cho COVID-19, đối với thuyên tắc mãn tính vẫn còn đang tranh cãi.
Phòng ngừa PC ILD và điều trị: Để giảm thiểu những yếu tố nguy cơ tiến triển đến PC-ILD cần rút ngắn thời gian nằm ICU, tránh thở máy xâm nhập nếu có thể, nếu cần thì thở áp lực thấp, điều trị các bệnh kèm và ngăn ngừa nhiễm trùng thứ phát. Các lựa chọn điều trị sau được liệt kê dựa trên những bằng chứng hiện tại:
a. Thuốc kháng virus:
Có mối quan hệ chặt chẽ giữa tiến triển xơ phổi và tải lượng virus cao, hiệu quả của các phương pháp điều trị kháng virus sớm (remdesivir, favipiravir) để giảm tải lượng virus đã được chứng minh trong một số nghiên cứu. Sự cần thiết của thuốc kháng virus trong việc kiểm soát đại dịch là không thể chối cãi. Tuy nhiên, chưa có loại thuốc đặc hiệu nào được phát triển cho SARSCoV-2 và nhiều nghiên cứu đang được tiến hành để phát triển các loại thuốc hiệu quả
b. Thuốc kháng viêm:
Hiệu quả của steroid toàn thân đã được chứng minh trong điều trị bệnh nhân COVID nặng giai đoạn cấp. Tuy nhiên, chưa đủ bằng chứng để sử dụng steroid lâu dài ngăn ngừa PC-ILD. Vài nghiên cứu đề xuất dùng liều 20–30 mg /ngày prednisolone ngay khi có sự hiện diện của hình ảnh kính mờ lan tỏa cho đến khi có sự cải thiện hình ảnh học.
c. Thuốc chống xơ phổi
Như đã đề cập, các tổn thương phổi có thể hồi phục nên có thể theo dõi hình ảnh trong tối đa 3 tháng, không cần thiết phải vội vàng dùng thuốc chống xơ phổi. Nếu xơ phổi vẫn còn tồn tại vào cuối tuần thứ 12, có thể sử dụng thuốc chống xơ, dù hiện nay vẫn chưa có đủ bằng chứng. Pirfenidone hoặc Nintedanib nên được sử dụng trong ít nhất 1-3 tháng để có được đáp ứng. Đáp ứng thuốc chống xơ nên được đánh giá bằng HRCT, DLCO và 6MWT. Có thể thử sử dụng đồng thời steroid và thuốc chống xơ phổi, tuy nhiên kết quả lâu dài vẫn chưa được biết rõ.
d. Phục hồi chức năng hô hấp
Là điều trị then chốt, có thể áp dụng được tại nhà. Khi PC DIL gây hạ oxy máu, việc sử dụng oxy dài hạn và phục hồi chức năng tại nhà có thể giúp cải thiện tình trạng này
e. Các biện pháp hỗ trợ khác:
Chống đông, hỗ trợ tâm lí, hỗ trợ từ gia đình, chích ngừa cúm và viêm phổi là cần thiết cho đến khi bệnh nhân có thể di động hoàn toàn. Đánh giá, theo dõi các trường hợp PC ILD tiến triển để xem xét ghép phổi
4.7. Thuyên tắc phổi dự phòng và điều trị
Sau giai đoạn cấp, tình trạng tăng đông vẫn có thể kéo dài, vì vậy dự phòng lâu dài có thể được khuyến cáo trong các trường hợp bệnh nặng. Tuy nhiên, vấn đề này còn đang bàn cãi. Trường hợp bệnh nặng kèm theo thuyên tắc phổi, dùng thuốc chống đông là bắt buộc theo các khuyến cáo guideline cụ thể. Khuyến cáo nên đánh giá sự tiến triển của tăng áp phổi (pulmonary hypertension PHT) sau 12 tuần và ngừng điều trị sau 3 tháng nếu tăng áp phổi chưa phát triển. Cuối cùng, việc đo và theo dõi D-Dimer, cũng là một chất phản ứng giai đoạn cấp và không đặc hiệu cho COVID-19, đối với thuyên tắc mãn tính vẫn còn đang tranh cãi.

4.8. Viêm phổi thứ phát
Viêm phổi thứ phát do vi khuẩn nên được quản lý bằng kháng sinh uống/ tiêm tĩnh mạch phù hợp theo các guideline. Lưu ý bệnh nhân sẽ có nguy cơ cao nhiễm vi khuẩn kháng thuốc và nấm phổi do phần lớn đã từng trải qua điều trị tại các cơ sở y tế giai đoạn cấp. Cần chú ý để loại trừ các tác nhân này ở bệnh nhân sốt, khạc đàm và/hoặc ho ra máu. Điều trị nên được thực hiện tại các trung tâm có kinh nghiệm với thuốc kháng nấm và/ hoặc can thiệp, thủ thuật thích hợp.
TÀI LIỆU THAM KHẢO:
1. Esendağli D, Yilmaz A, Akçay Ş, Özlü T. Post-COVID syndrome: pulmonary complications. Turk J Med Sci. 2021;51(SI-1):3359-3371. Published 2021 Dec 17. doi:10.3906/sag-2106-238
2. NATIONAL COMPREHENSIVE GUIDELINES FOR MANAGEMENT OF POSTCOVID SEQUELAE Ministry of Health and Family Welfare Government of India
3. Crook H, Raza S, Nowell J, Young M, Edison P. Long covid mechanisms, risk factors, and management BMJ 2021; 374 :n1648 doi:10.1136/bmj.n1648
4. Zoumot Z Bonilla MF Wahla AS Shafiq I Uzbeck M Pulmonary cavitation: an under-recognized late complication of severe COVID-19 lung disease. BMC Pulmonary Medicine. 2021;21:24–24
5. Cho JL Villacreses R Nagpal P Guo J Pezzulo AA Small Airways Disease is a Post-Acute Sequelae of SARS-CoV-2 Infection.
6. Udwadia ZF Koul PA Richeldi L Post-COVID lung fibrosis: The tsunami that will follow the earthquake. Lung India. 2021;38:S41–S47
7. Korompoki E Gavriatopoulou M Hicklen RS Ntanasis-Stathopoulos I Kastritis E Epidemiology and organ specific sequelae of post-acute COVID19: A narrative review. Journal of Infection
Viêm phổi thứ phát do vi khuẩn nên được quản lý bằng kháng sinh uống/ tiêm tĩnh mạch phù hợp theo các guideline. Lưu ý bệnh nhân sẽ có nguy cơ cao nhiễm vi khuẩn kháng thuốc và nấm phổi do phần lớn đã từng trải qua điều trị tại các cơ sở y tế giai đoạn cấp. Cần chú ý để loại trừ các tác nhân này ở bệnh nhân sốt, khạc đàm và/hoặc ho ra máu. Điều trị nên được thực hiện tại các trung tâm có kinh nghiệm với thuốc kháng nấm và/ hoặc can thiệp, thủ thuật thích hợp.
TÀI LIỆU THAM KHẢO:
1. Esendağli D, Yilmaz A, Akçay Ş, Özlü T. Post-COVID syndrome: pulmonary complications. Turk J Med Sci. 2021;51(SI-1):3359-3371. Published 2021 Dec 17. doi:10.3906/sag-2106-238
2. NATIONAL COMPREHENSIVE GUIDELINES FOR MANAGEMENT OF POSTCOVID SEQUELAE Ministry of Health and Family Welfare Government of India
3. Crook H, Raza S, Nowell J, Young M, Edison P. Long covid mechanisms, risk factors, and management BMJ 2021; 374 :n1648 doi:10.1136/bmj.n1648
4. Zoumot Z Bonilla MF Wahla AS Shafiq I Uzbeck M Pulmonary cavitation: an under-recognized late complication of severe COVID-19 lung disease. BMC Pulmonary Medicine. 2021;21:24–24
5. Cho JL Villacreses R Nagpal P Guo J Pezzulo AA Small Airways Disease is a Post-Acute Sequelae of SARS-CoV-2 Infection.
6. Udwadia ZF Koul PA Richeldi L Post-COVID lung fibrosis: The tsunami that will follow the earthquake. Lung India. 2021;38:S41–S47
7. Korompoki E Gavriatopoulou M Hicklen RS Ntanasis-Stathopoulos I Kastritis E Epidemiology and organ specific sequelae of post-acute COVID19: A narrative review. Journal of Infection
Tác giả: Khoa Nội tim mạch – Bệnh viện Đa khoa tỉnh Quảng Trị
Từ khóa: hô hấp
Ý kiến bạn đọc
Bạn cần đăng nhập với tư cách là Thành viên chính thức để có thể bình luận
Những tin mới hơn
Những tin cũ hơn
Kiến thức y khoa
Góc tri ân
Album ảnh bệnh viện
-
 Tọa đàm ngày Quốc tế phụ nữ 8.3.2019
Tọa đàm ngày Quốc tế phụ nữ 8.3.2019
-
 Thành lập đơn vị đột quỵ - thầy thuốc ưu tú
Thành lập đơn vị đột quỵ - thầy thuốc ưu tú
thành lập đơn vị đột quỵ - thầy thuốc ưu tú
-
 Ngày thầy thuốc Việt Nam 27.2.2018
Ngày thầy thuốc Việt Nam 27.2.2018
ngày thầy thuốc Việt Nam 27.2.2018
-
 Hội thi quy tắc ứng xử 2018
Hội thi quy tắc ứng xử 2018
hội thi quy tắc ứng xử 2018
-
 Hội nghị khoa học tiết niệu 12.4.2019
Hội nghị khoa học tiết niệu 12.4.2019
Bạn đã không sử dụng Site, Bấm vào đây để duy trì trạng thái đăng nhập. Thời gian chờ: 60 giây
Gửi phản hồi